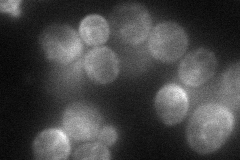
YDR093W
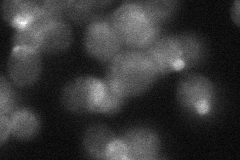
YDR093W
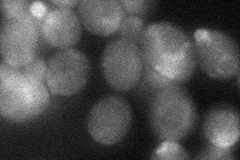
YDR093W

View description
Aminophospholipid translocase (flippase) that localizes primarily to the plasma membrane; contributes to endocytosis, protein transport and cell polarity; type 4 P-type ATPase
Localization:
Intensity:
Fold change:
Significance:
-
C’ GFP library in SD

cell periphery30.13 -
N' NOP1pr-GFP in SD
cell periphery,ER,bud neck57.2795 -
N' TEF2pr-mCherry in SD

ER,bud neck64.3303 -
N' NATIVEpr-GFP in SD
cell periphery,bud23.3916 -
N' TEF2pr-VC and Cyto-VN in SD
punctate,bud neck39.4601 -
C’ GFP library in SD+DTT

cell periphery34.841.15No -
C’ GFP library in SD+H2O2

cell periphery29.660.98No -
C’ GFP library in Starvation Media

cell periphery22.090.73Yes -
C’ GFP library on the background of Pup2-DaMP

cell periphery -
C’ GFP library on the background of CCT mutant

cell periphery21.19220.703285No
